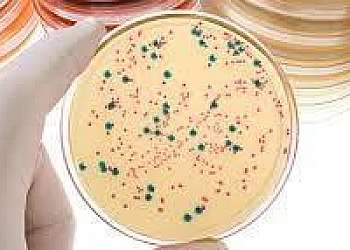

Buscas relacionadas:
Análise de água
Possuindo centenas de empresas, o Soluções Industriais é a plataforma business to business mais completo do ramo industrial.
Para realizar uma cotação de Análise de água, clique em um dos anunciantes a seguir:

Buscas relacionadas:
Possuindo centenas de empresas, o Soluções Industriais é a plataforma business to business mais completo do ramo industrial.
Para realizar uma cotação de Análise de água, clique em um dos anunciantes a seguir: